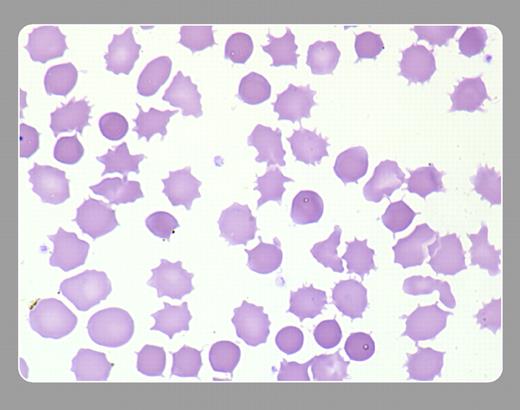
Figure 1. Acanthocytes are red cells that have a spherical core and a spiculated appearance. A typical acanthocyte lacks central pallor and has from 3 to 12 “spikes” or “knobs.” They can be seen in advanced liver disease (where they are referred to as spur cells), abetalipoproteinemia, and, occasionally, after splenectomy. . / Peter Maslak, Memorial Sloan-Kettering Cancer Center

Acanthocytes are red cells that have a spherical core and a spiculated appearance. A typical acanthocyte lacks central pallor and has from 3 to 12 “spikes” or “knobs.” They can be seen in advanced liver disease (where they are referred to as spur cells), abetalipoproteinemia, and, occasionally, after splenectomy.
Peter Maslak, Memorial Sloan-Kettering Cancer Center
Acanthocytes are red cells that have a spherical core and a spiculated appearance. A typical acanthocyte lacks central pallor and has from 3 to 12 “spikes” or “knobs.” They can be seen in advanced liver disease (where they are referred to as spur cells), abetalipoproteinemia, and, occasionally, after splenectomy.
Peter Maslak, Memorial Sloan-Kettering Cancer Center
Many Blood Work images are provided by the ASH IMAGE BANK, a reference and teaching tool that is continually updated with new atlas images and images of case studies. For more information or to contribute to the Image Bank, visit www.ashimagebank.org.